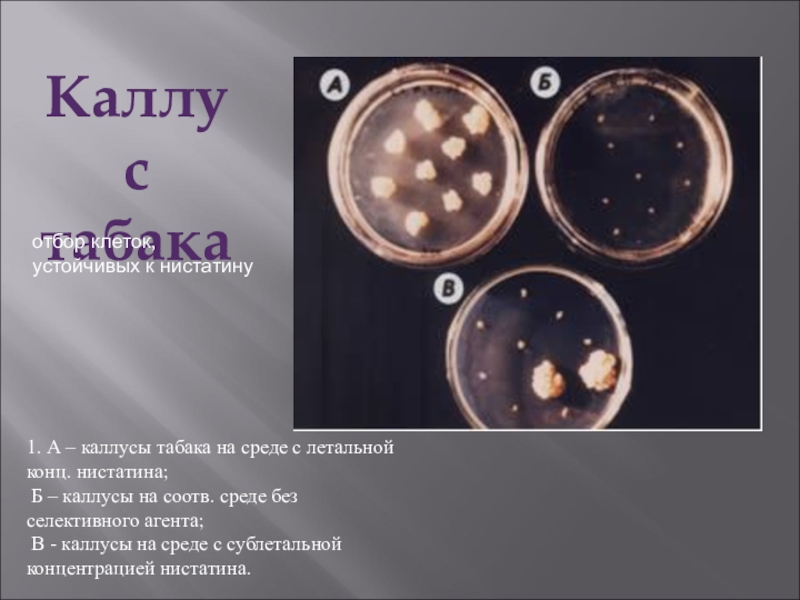

- Главная
- Разное
- Образование
- Спорт
- Естествознание
- Природоведение
- Религиоведение
- Французский язык
- Черчение
- Английский язык
- Астрономия
- Алгебра
- Биология
- География
- Геометрия
- Детские презентации
- Информатика
- История
- Литература
- Математика
- Музыка
- МХК
- Немецкий язык
- ОБЖ
- Обществознание
- Окружающий мир
- Педагогика
- Русский язык
- Технология
- Физика
- Философия
- Химия
- Шаблоны, фоны, картинки для презентаций
- Экология
- Экономика
Презентация, доклад на тему Получение каллусной ткани из листьев табака
Содержание
- 1. Получение каллусной ткани из листьев табака
- 2. Получение каллусной ткани из листьев табакаТабак -
- 3. Каллусообразование очень хорошо идет у основания листьев
- 4. Материалы и оборудование необходимые для получения каллуса
- 5. Листья табака промывают в мыльном растворе, отмывают
- 6. Каллус табака
- 7. 1. А – каллусы табака на среде
- 8. Каллусная ткань табакаКаллус табака, полученный из единичных клеток
- 9. Органогенный каллус,полученный из каллуса табака при его перенесениина среду с цитокинином
- 10. Регенерация растенийтабака из органогенного каллуса
- 11. Образование стеблевых почек тканью табака
- 12. Растение табака полученное из одной клетки
- 13. Слайд 13
Получение каллусной ткани из листьев табакаТабак - классический объект для получения каллусной ткани и дальнейших ее исследований. Клетки табака легко дедифференцируются и переходят к делению, образуя быстро растущую каллусную ткань. Кроме того, в каллусной ткани табака
Слайд 2Получение каллусной
ткани из листьев табака
Табак - классический объект для получения
каллусной ткани и дальнейших ее исследований. Клетки табака легко дедифференцируются и переходят к делению, образуя быстро растущую каллусную ткань. Кроме того, в каллусной ткани табака легко вызвать регенерацию.
Слайд 3Каллусообразование очень хорошо идет у основания листьев табака, особенно в зоне,
примыкающей к срединной жилке. Для получения каллуса пригодны как стерильные, так и нестерильные растения. Нестерильные растения стерилизуют в растворе хлорамина, перекиси водорода или других стерилизующих агентов.
Слайд 4Материалы и оборудование
необходимые
для получения каллуса табака
1.растения табака любого возраста(
стерильные или нестерильные),
2. этанол, 4% раствор хлорамина
3. пробирки со стерильной водой (3 штуки), 4.скальпель, пинцет, спиртовка
5. кафельная плитка, стаканчик, подставки для инструмента, кисточка
6. чашка Петри, спички,
7. пробирки со средой
2. этанол, 4% раствор хлорамина
3. пробирки со стерильной водой (3 штуки), 4.скальпель, пинцет, спиртовка
5. кафельная плитка, стаканчик, подставки для инструмента, кисточка
6. чашка Петри, спички,
7. пробирки со средой
Для культивирования каллусов из листьев табака используют среду Мурасиге-Скуга с добавлением ауксинов
Слайд 5Листья табака промывают в мыльном растворе, отмывают от мыла водопроводной водой,
ополаскивают дистиллированной. Погружают на 1 минуту в стаканчик с этанолом, вынимают, после чего помещают в чашку Петри и заливают стерилизующим раствором на 10 минут. Раствор слить, промыть трижды стерильной дистиллированной водой из пробирок, в каждой из порций держать не менее 5 минут.
Если берутся пробирочные растения, то предварительная стерилизация не требуется.
Стерильные листья табака положить на предварительно обожженую кафельную плитку, стерильным скальпелем вырезать фрагменты у основания листьев, прилегающие к средней жилке, длиной 1-1.5 см, шириной 1 см. Перенести подготовленные участки листьев в пробирки или чашки Петри с питательной средой МС, содержащей гормоны, поместить в термостат при температуре 26 градусов С. Через 3 недели рассмотреть и зарисовать результат.
Если берутся пробирочные растения, то предварительная стерилизация не требуется.
Стерильные листья табака положить на предварительно обожженую кафельную плитку, стерильным скальпелем вырезать фрагменты у основания листьев, прилегающие к средней жилке, длиной 1-1.5 см, шириной 1 см. Перенести подготовленные участки листьев в пробирки или чашки Петри с питательной средой МС, содержащей гормоны, поместить в термостат при температуре 26 градусов С. Через 3 недели рассмотреть и зарисовать результат.
Ход работы
Слайд 71. А – каллусы табака на среде с летальной конц. нистатина;
Б – каллусы на соотв. среде без селективного агента;
В - каллусы на среде с сублетальной концентрацией нистатина.
Каллус
табака
отбор клеток, устойчивых к нистатину